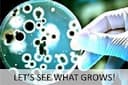
Thumbnail 7

🔬 Unleash the Scientist Within!
The Student Plus+ Bacteria Growing Science Fair Kit is a comprehensive educational tool designed for young aspiring scientists. It includes four pre-poured agar plates, sterile swabs, gloves, and a free eBook guide, making it perfect for hands-on learning in microbiology. Ideal for students aged 13 and up, this kit promotes STEM education while ensuring safety and ease of use.
| ASIN | B077GLCC66 |
| Date First Available | September 22, 2018 |
| Is Discontinued By Manufacturer | No |
| Manufacturer | Diamante Scientific |
| Product Dimensions | 4 x 4 x 6 inches |
J**D
Not worth it
Broken upon arrival
Trustpilot
Hace 3 días
Hace 2 días
Hace 2 semanas
Hace 1 mes